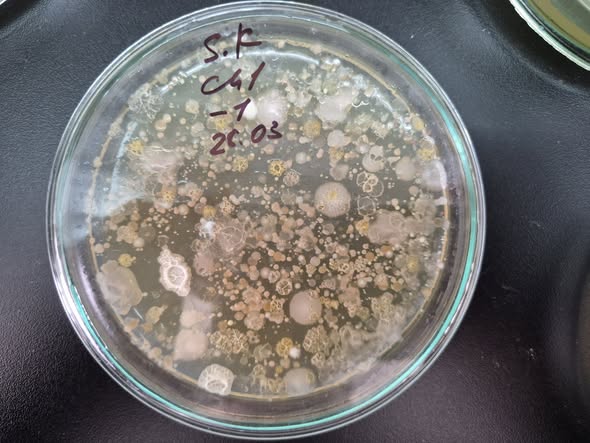

Ўзбек олимлари тупроқ намлигини сақлайдиган ва унумдорлигини оширадиган бактерияларни кашф қилди
Бу бактериялар сувни ўзига бириктириб, маълум муддат сақлай оладиган биологик полимерлар ҳосил қилади. Мазкур биополимерлар тупроқ намлигини сақлайди, тупроқларни унумдор қилади, шўрни камайтиради.
Фан-технология
05.12.2025, 11:25
Улашиш:

Ўзбекистонлик олимлар томонидан олиб борилган илмий тадқиқотлар натижасида гиёҳ унмайдиган, сув юрмайдиган адир тупроқларидан қатор бактерия штаммлари ажратиб олинди. Мазкур микроорганизмлар тупроқда сувни ушлаб қолиш ва унинг унумдорлигини оширишда муҳим аҳамиятга эга.
Маълум қилинишича, Чуст адирлари тупроқларидан топилган бактериялар сувни ўзига бириктириб, маълум муддат сақлаб тура оладиган биологик полимерлар ҳосил қилади. Бу биополимерлар тупроқ намлигини барқарор сақлаш, шўрланишни камайтириш ва ернинг унумдорлигини оширишга ёрдам беради.
Олимларнинг таъкидлашича, иқлим ўзгариши фонида йилдан-йилга қурғоқлашиб бораётган ҳудудларда бундай биотехнологик усуллар кейинги йилларда тобора долзарб аҳамият касб этади. Мавжуд ресурслардан унумли фойдаланиш ва тупроқни тиклашда ана шундай бактериялар муҳим ўрин тутиши мумкинлиги қайд этилди.
Тадқиқотчилар фикрига кўра, мазкур штаммлар қишлоқ хўжалиги учун янгича имконият яратиб, сув танқислиги кузатиладиган ҳудудларда ер сифатини сақлаб қолишга хизмат қилиши мумкин.
Фан-технология
05.12.2025, 11:25
Улашиш:
машҳур янгиликлар

Алимент тўловчилар чет давлатга чиқиши мумкин бўлади
Ўзбекистон
27.11.2025, 09:55

Ўзбекистонда эко-стикер тизими қачондан амал қилади?
Ўзбекистон
05.12.2025, 17:01

Тошкент ҳавосининг ифлосланишига қарши курашишнинг энди иложи йўқми?
Ўзбекистон
28.11.2025, 16:27

АҚШ 19 давлат учун виза беришни вақтинча тўхтатди
Жаҳон
04.12.2025, 09:23

«Бу нарса тўхташи керак»: Саида Мирзиёева Қибрайдаги иссиқхонада экологик текширув ўтказди
Ўзбекистон
03.12.2025, 10:05

Блогер Real Sanjik товламачилик ва ноқонуний қурол сақлашда гумонланиб қўлга олинди
Ўзбекистон
28.11.2025, 14:26
сўнгги янгиликлар

Тошкентда тунда бепул паркинг жорий этилади: кимлар фойдалана олади?
Иқтисодиёт
26.12.2025, 14:38

«Экостикер» тизими: 2026 йилдан жарималар қўлланилмайди
Ўзбекистон
26.12.2025, 10:13

Акмал Шукуров иши: апелляцияда қарор чиқарган судялар лавозимидан четлатилди
Ўзбекистон
26.12.2025, 09:31

Ходимларга Янги йил мукофоти берилиши шартми?
Ўзбекистон
25.12.2025, 13:57

Россиянинг ҳафталик ҳарбий харажатлари 62 та ҳудуднинг йиллик бюджетидан ошди
Жаҳон
25.12.2025, 12:06

"Келишув бузилди". “Ўткан кунлар” таржимони нимадан норози?
Маданий
25.12.2025, 10:55

Италия Apple’га 98,6 миллион евро жарима солди
Жаҳон
25.12.2025, 08:01

Дунёда энг арзон бензин қаерда?
Жаҳон
24.12.2025, 17:37

Йиртқичлар асрида кучли бўлишимиз керак - Макрон
Жаҳон
24.12.2025, 14:40

Антикоррупция агентлиги 2025 йилда олинган совғалар рўйхатини ошкор қилмади
Ўзбекистон
24.12.2025, 12:05

Янги йил муносабати билан кетма-кет 5 кун дам олиш мумкин бўлади
Ўзбекистон
24.12.2025, 09:34

Янги уй-жой харид қилган харидорга кэшбек берилади
Иқтисодиёт
23.12.2025, 18:07
машҳур янгиликлар

Алимент тўловчилар чет давлатга чиқиши мумкин бўлади
Ўзбекистон
27.11.2025, 09:55

Ўзбекистонда эко-стикер тизими қачондан амал қилади?
Ўзбекистон
05.12.2025, 17:01

Тошкент ҳавосининг ифлосланишига қарши курашишнинг энди иложи йўқми?
Ўзбекистон
28.11.2025, 16:27

АҚШ 19 давлат учун виза беришни вақтинча тўхтатди
Жаҳон
04.12.2025, 09:23

«Бу нарса тўхташи керак»: Саида Мирзиёева Қибрайдаги иссиқхонада экологик текширув ўтказди
Ўзбекистон
03.12.2025, 10:05

Блогер Real Sanjik товламачилик ва ноқонуний қурол сақлашда гумонланиб қўлга олинди
Ўзбекистон
28.11.2025, 14:26
